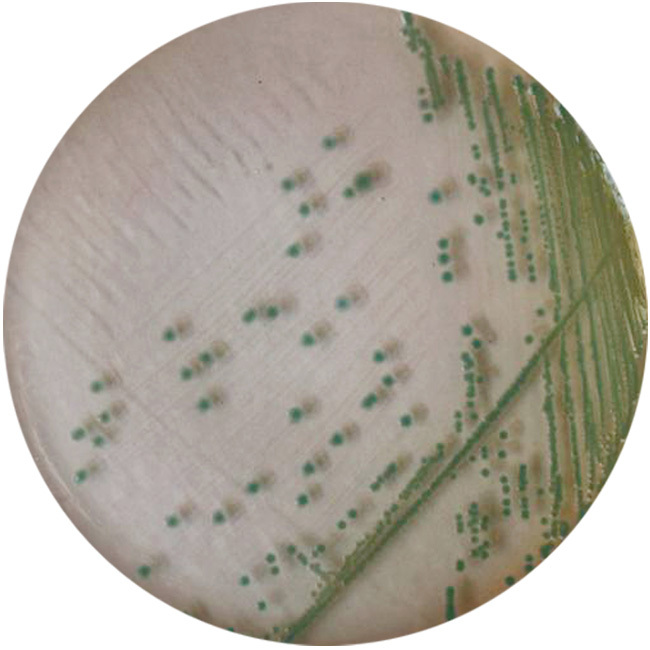
鳗弧菌
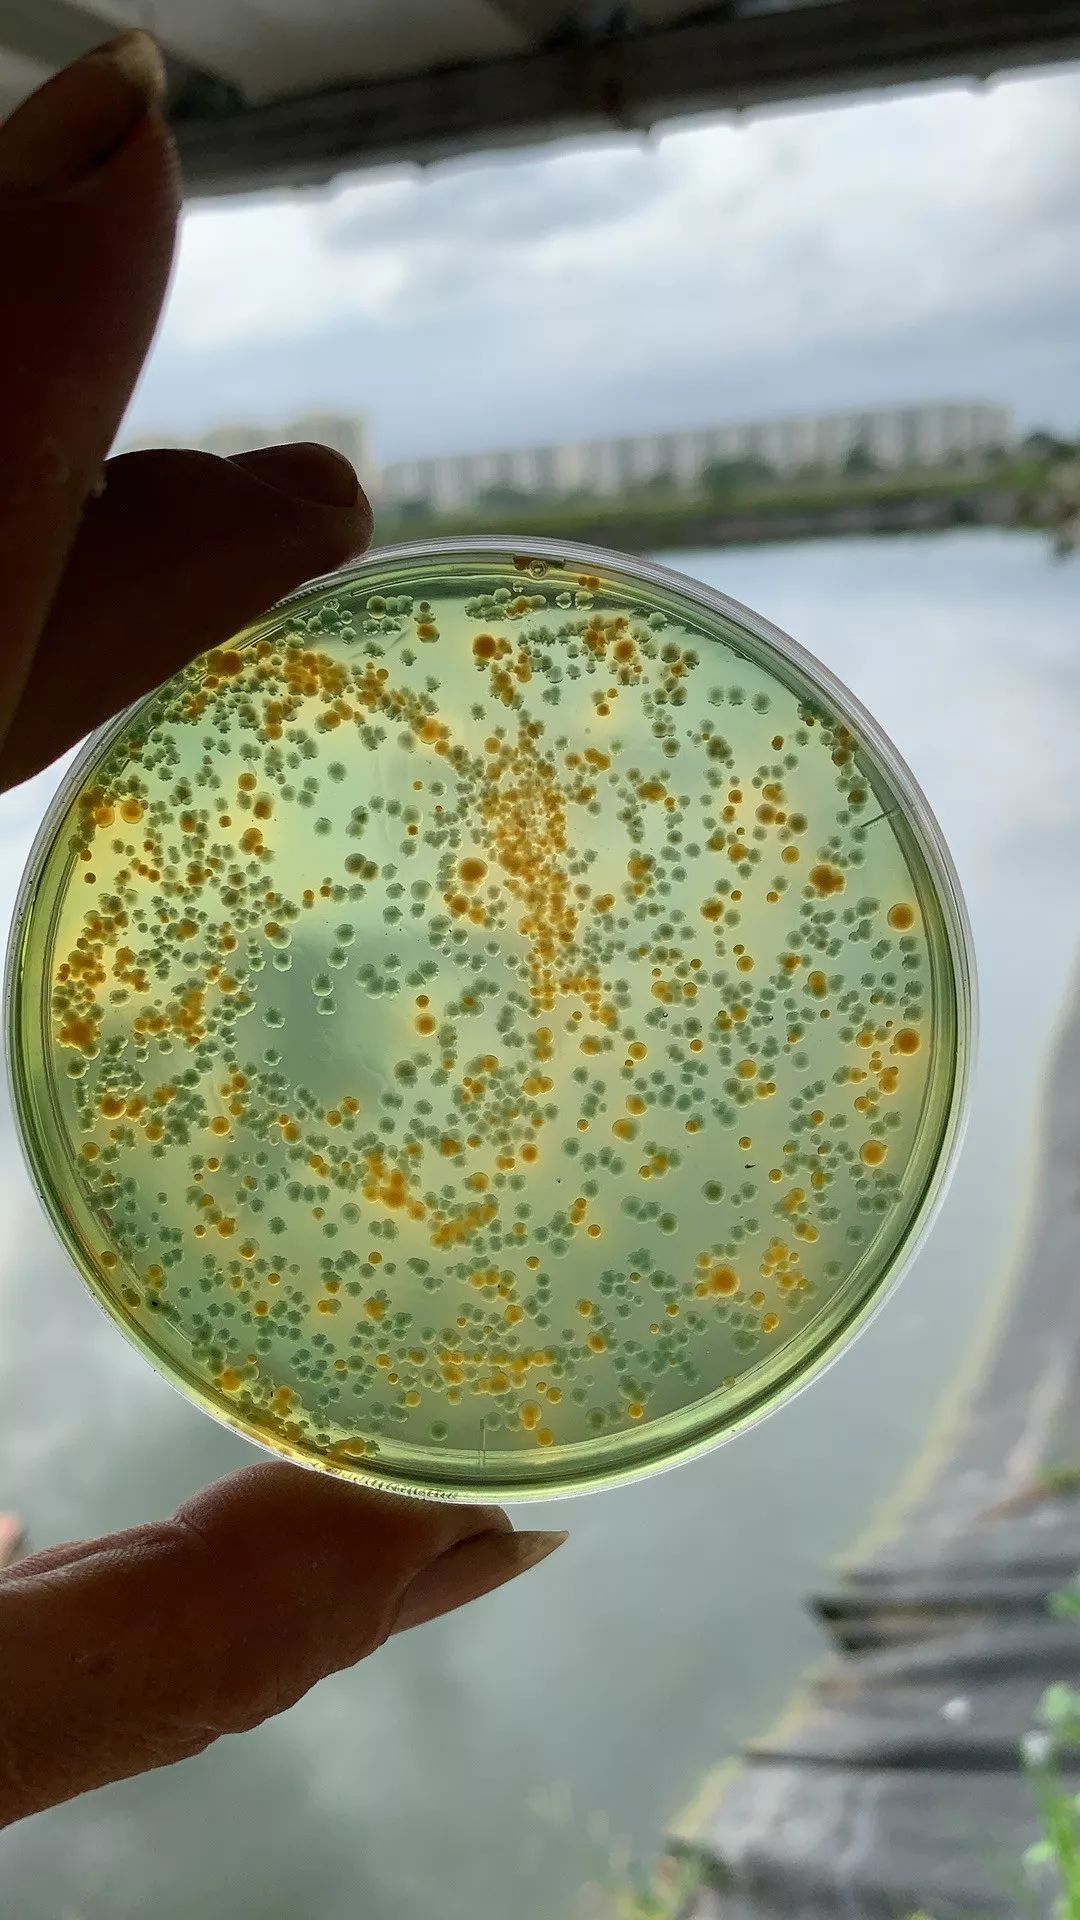
高温对南美白对虾养殖的影响
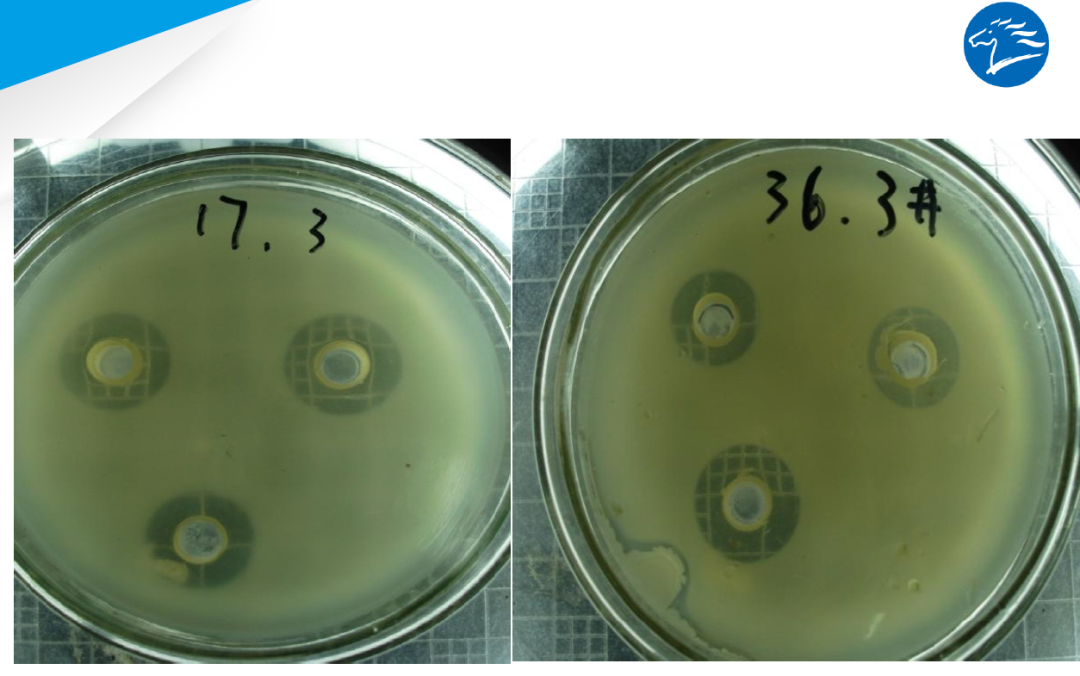
天马鳗乳素业内首创无抗动保模式解决鳗鱼肠炎呵护肝胆健康

鳗弧菌

蛭弧菌图片_百度百科
图片尺寸150x120
鳗弧菌
图片尺寸650x650
高温对南美白对虾养殖的影响
图片尺寸1080x1920
鳗弧菌
图片尺寸339x209
自2003年起,采取对中国牙鲆人工感染鳗弧菌的途径选育出抗病选育群
图片尺寸559x241
收藏蛭弧菌在水产养殖中的妙用
图片尺寸800x440
天马鳗乳素业内首创无抗动保模式解决鳗鱼肠炎呵护肝胆健康
图片尺寸1080x676
弧菌主要有副溶血弧菌,创伤弧菌,哈维氏弧菌,溶藻弧菌,鳗弧菌,霍乱
图片尺寸891x892
能影响到鱼虾的弧菌类型实在太多了,比如:副溶血弧菌,溶藻弧菌,鳗弧菌
图片尺寸600x300
爆发弧菌病有什么方法可以抑制吗
图片尺寸640x480
哈维弧菌与发光细菌疾病有关,鳗弧菌是攻击幼虾并导致大量死亡的主要
图片尺寸588x670
鳗弧菌通过吸附并入侵鱼体的通道主要包括皮肤,鳃,侧线和肠道,目前
图片尺寸1080x1439
相关产品创伤弧菌是严重海产品相关感染的病原体照片
图片尺寸533x300
里的弧菌 【病因】 引起河蟹弧菌病的病原有多种弧菌,其中包括鳗弧菌
图片尺寸1002x461
水产养殖弧菌病很头疼?看看 优弧灵>是如何解决的吧!
图片尺寸1200x901
南美白对虾养殖过程中弧菌的那些事儿
图片尺寸660x700
病因引起烂鳍病的病原菌常见有嗜水气单胞菌,荧光假单胞菌和鳗弧菌等.
图片尺寸580x341
黄弧菌:溶藻弧菌,霍乱弧菌,哈维氏弧菌,鳗弧菌.
图片尺寸660x800
弧菌病害防治:水产养殖中一种不得不防的致病菌
图片尺寸1200x855
1,病原 常见的有鳗弧菌(vibrio anguillarum),溶藻弧菌(v.
图片尺寸1747x820